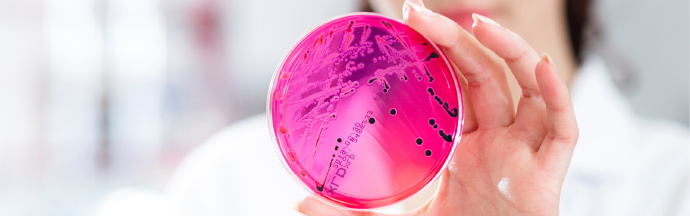

新版欧盟医疗器械法规MDR于2021年5月26日正式生效!
为更好地保护患者安全和公众健康,医疗器械制造商迎来一场全新的法规变革:新版欧盟医疗器械法规,简称MDR,于2021年5月26日正式生效,取代医疗器械指令(93/42/EEC)和有效植入式医疗器械指令(90/385/EEC)。新法规将更加关注临床性能、医疗器械的可追溯性和透明性;要求制造商提供产品的质量管理流程和风险管理系统,包括全面的临床评估证明——这意味着进入欧洲市场的医疗器械将被实施更严格的限制。
作为德国认可委员会(DAKKS)认证的医疗产品检测机构,海恩斯坦主要专长之一是检测一类医疗器械:除根据DIN EN 14683测试医用口罩外,还可根据DIN EN 13795分析手术用纺织品的性能及有效性,并根据RAL-GZ 387 标准测试压力袜性能。基于DIN EN ISO 10993系列标准进行生物相容性测试,包括DIN EN ISO 10993-5细胞毒性和DIN EN ISO 10993-18化学表征。
产品功效和安全性符合欧洲医疗器械法规(MDR)是进入欧洲市场的先决条件。作为经认证的医疗产品检测实验室,海恩斯坦为提供快速专业的测试证明,测试医疗器械的有效性和安全性,用于技术文件,风险评估和临床评估。
-
01.手术用纺织品海恩斯坦实验室根据DIN EN13795分析手术用纺织品的性能和有效性

-
02.医用口罩
根据DIN EN 14683附录B,检测细菌过滤效率(BFE)
根据DIN EN 14683附录C,测定透气性(压力差)
根据ISO 22609,检测人造血液的渗透率微生物清洁度(生物负载)和生物相容性的评价

-
03.外科手术衣、手术用消毒帷帘和洁净服
根据DIN EN ISO 22610,检测潮湿状态下的抗病菌渗透能力
根据DIN EN ISO 22612,检测干燥状态下的抗病菌渗透能力
根据DIN EN ISO 9073-10,检测干燥状态下的颗粒释放(掉毛)
根据EN ISO 13938-1,检测干湿状态下的顶破强力
根据EN ISO29073-3,检测干湿状态下的拉伸强力微生物清洁度/生物负载和生物相容性的评价

-
04.压力袜作为德国医用压力袜认证协会授权实验室,海恩斯坦拥有自主研发的HOSYcan测试装置——压力测试系统。该装置可以更精确、灵活地测量压力强度和压力分布,甚至测量运动中的压缩性能。它适用于所有压力纺织品,如医用压力纺织品和压力袖套、护膝、护踝、抗血栓袜、具有压缩性能的运动服、塑身衣等。

-
05.生物相容性
DIN EN ISO10993-5细胞毒性
DIN EN ISO10993-18化学表征
通过HET CAM试验来测试刺激性/粘膜损伤
根据要求进行进一步测试

-
06.微生物纯度,清洗/再加工
根据DIN EN ISO 11737-1,检测微生物数量(生物负载)
根据DIN EN ISO 6330(家居洗衣)和DIN EN ISO 15797(工业洗衣)的标准清洗程序进行再加工
卫生监测/微生物环境测试,例如生产环境
-
07.老化与保质期
对医疗器械在全新状态下和老化后的功能和生物相容性进行对比测试
人工气候室中进行加速保质期试验
标准条件下进行实时保质期试验

-
08.其他医疗器械
使用扫描电子显微镜(SEM)和SEM-EDX检测表面状况和损伤模式
根据AiF11283,检测矫形器和绷带的微气候/生理功能
根据DIN Spec13257,检测足部绷带的功能在人体皮肤上进行机械刺激/耐磨试验
通过放射性标记和LSC洗脱/残留生物成分(如涂层、活性成分)
抗菌活性符合DIN EN ISO20743,抗病毒活性符合ISO18184






















































































